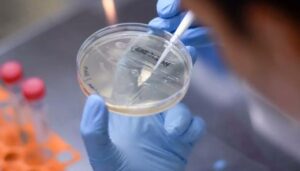

El Sumario – La variante delta del coronavirus causante del Covid-19, detectada primero en la India y presente en más de 70 países, va camino de ser la dominante en el mundo debido a su mayor capacidad de transmisión.
Así lo advirtió este viernes 18 de junio la jefa de científicos de la Organización Mundial de la Salud (OMS), Soumya Swaminathan.
Dicha variante «se está volviendo más prominente y dominante en algunas partes y esto es preocupante dada la información que tenemos sobre su transmisibilidad», añadió el director de Emergencias Sanitarias de la OMS, Mike Ryan.
Reducir las restricciones de salud pública o declarar una victoria prematura contra la pandemia podría contribuir a la expansión de esta variante
Los expertos coincidieron en que la situación de la pandemia aún es muy dinámica, debido a las variantes que están circulando.
La variante delta es un 70% más transmisible que la alfa (detectada primero en Reino Unido), que a su vez era un 50% más contagiosa que la cepa original.
Los expertos recordaron que reducir las restricciones de salud pública o declarar una victoria prematura contra la pandemia podría contribuir a la expansión de esta variante.
Le puede interesar: Papa Francisco pide por una “reforma a fondo de la economía”
Gerardo Contreras
Con información de medios internacionales